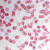
腫瘍細胞のアポトーシスを誘導

ご質問
- フコイダンってなんですか?
- フコイダンの種類によって違いはあるんですか?
- モズクを食べるだけでも効果はありますか?
- がん治療に効果がある、アポトーシスってなんですか?
- フコイダンにもアポトーシス作用はあるの?
1.フコイダンってなんですか?
モズクやコンブ、ワカメなどの褐藻類やナマコの表面に含まれるヌルヌル成分のことです。
陸上では、カエルの卵のゼリー質にしか見つかっておりません。
もっと知りたいリンク
フコイダンとは
フコイダンの概説、効果・効能を説明しています。
トンガ王国産のフコイダンの特徴
トンガ王国産のフコイダンの特徴を紹介しています。
2.フコイダンの種類によって違いはあるんですか?
モズクやワカメ・コンブなどの種類によるフコイダンの効能には大きな差はありませんが、フコイダンの抽出のときに13%~20%ある「硫酸基」をはずさないということが重要です。ここでいう硫酸基とは劇薬である硫酸の元になっている成分で、単体で存在する時は劇薬にもなりますが、有機物と結合した状態を「硫酸基」といいます。
我々の研究によると、この「硫酸基」が13%以上結合していないとフコイダンの機能を十分に発揮しないと考えています。
もっと知りたいリンク
機能を発揮するための条件
機能を発揮するには、一定以上の結合された分子構造(硫酸基)を形成している必要があります。
フコイダンを選ぶ基準とは
様々なフコイダン製品がありますので、正しく選ぶ基準を記載しました。
3.モズクを食べるだけでも効果はありますか?
もちろん効果はありますが、健康や病気の予防・治療を目的にフコイダンを摂取しようとすると、大量のモズクを食べ続けなければなりません。
これは、栄養のバランスが偏ったり、塩分の過剰摂取などにもつながります。さらに大きな問題として、モズクをたくさん食べたとしても、残念ながら私たち人間の身体にはモズクなどの海藻を分解する酵素を持ち合わせていないため、フコイダンは体内に消化吸収されずに、ほとんどが体外に排出されてしまうのです。
ですので、一般的にはフコイダンは健康食品などから摂取することが効果的だと考えられます。
4.がん治療に効果がある、アポトーシスってなんですか?
生物のすべての細胞は、自分自身を死滅させる(自殺する)スイッチを持っています。(がん細胞も同様)例えば、オタマジャクシがカエルになるときしっぽがなくなるのは、しっぽの細胞が自ら死滅(自殺)するからです。こうした細胞の自滅
(自殺)作用を「アポトーシス」といい、あらかじめ遺伝的プログラムの中に組み込まれているという意味で、プログラム細胞死とも呼ばれます。しかし、がん細胞はアポトーシスを忘れた異常な細胞なので、自然死しないでいつまでも生き続けます。(転移・再発)そこで、がん細胞にアポトーシスを引き起こすことができれば増殖を止めて、がん細胞を自然死させることができるわけです。そのため、がん細胞にアポトーシスを誘導できる物質は、近年有力な抗がん剤候補物質と考えられ、様々な研究が進められています。
もっと知りたいリンク
腫瘍細胞のアポトーシスを誘導
プログラムに従って自然死する事を、アポトーシスといいます。
5.フコイダンにもアポトーシス作用はあるの?
近年、フコイダンにはアポトーシス誘導作用があるかのように宣伝する風潮が大変多くみられますが、それは大きな間違いです。フコイダン自体には、アポトーシスを誘導する作用は一切ありません。しかし、モズクにはアポトーシスを誘導できる物質が含まれており、現在その研究が進められています。この研究結果がわかり次第、いち早く皆様にご報告をしてまいります。
もっと知りたいリンク
腫瘍細胞のアポトーシスを誘導
プログラムに従って自然死する事を、アポトーシスといいます。